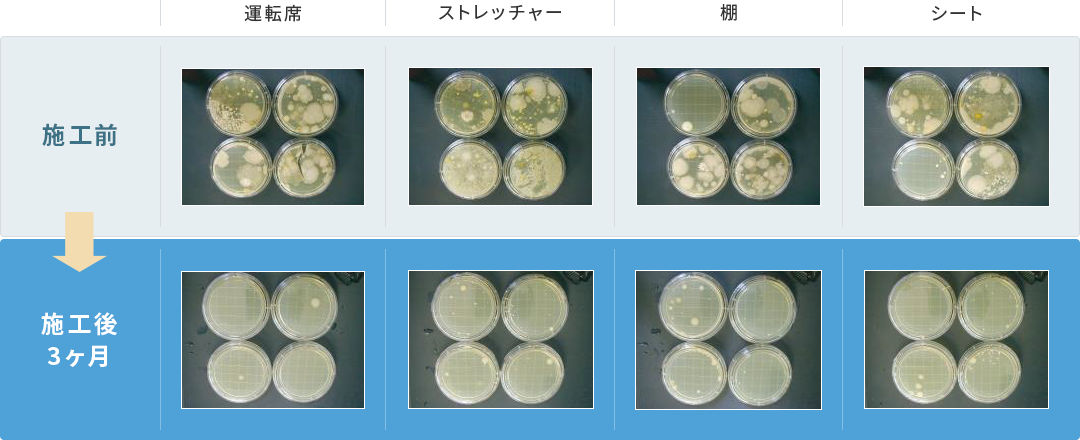
施工前から施工後3ヶ月の変化の写真(運転席、ストレッチャー、棚、シート)

導入メリットADVANTAGES
ルミストの
導入メリット
メリット1感染予防対策

一般的に感染経路には、【飛沫感染】【接触感染】【空気感染】があり、感染原因の80%と言われているのが接触感染です。
ルミストは、ドアノブから受話器やパソコンのキーボードなど、人が接触するスポットをはじめ施設全体をコーディングし、接触感染予防対策を行います。
※参考:米国疾病予防管理センター(CDC)
メリット2衛生環境の向上

抗ウイルス、抗菌、防臭、防カビと職場の衛生環境を向上させることにより、従業員の満足度が高まり、モチベーションアップにもつながるとこで生産性の向上に繋がります。
室内に漂うたばこ臭、カビ臭、加齢臭、など嫌な臭いからも守ります。
メリット3企業イメージの向上

施設の抗ウイルス・抗菌の施工実施を証明する証書およびシールを発行しています。
企業の信頼性や安心感、健康管理・危機管理への意識の高さなどブランドイメージの向上につなげます。
「抗ウイルス・抗菌コーティングを実施した」という事実を対外的に広報することが可能です。

施工事例 救急車の効果測定
救急車内各箇所における菌の増殖具合を検査した結果
施工前と施工後では、写真の菌の増殖具合が全く違います。この効果の持続性は約1年間という検査結果が出ています。
救急車内各箇所におけるATP検査した結果
ATP(アデノシン三リン酸)は地球上のすべての生物のエネルギー源として存在する物質で、生命活動が行われている所には必ず存在します。
例えば動物・植物・菌が持っており、そこから発生する「体液」「死骸」「植物残渣」等にも存在します。
つまり「ATPが存在する」ということは、「生物、あるいは生物の痕跡が存在する」証拠であり、菌の餌が存在する環境であるといえます。
キッコーマンバイオケミファ社製のルミテスターを用い、
救急車輌内の3箇所でATP量の測定を実施いたしました。


ATP量が3ヶ月後でも定期消毒後の施工前数値よりも下回っていることが確認できます

